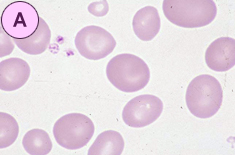
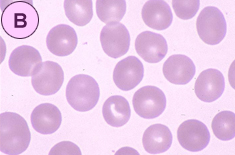

Q12. 適切と思われる赤血球形態像を下記より選んで下さい。 解答と解説
![]() |
![]() |
|
|---|---|---|
![]() |
||
| 選択細胞 | |
| 1 | 正常赤血球(discocyte) |
|---|---|
| 2 | 大小不同がみられる。 |
| 3 | 大型赤血球(macrocyte)がみられる。 |
| 4 | 破砕赤血球(schizocyte)がみられる。 |
| 5 | 有口赤血球(stomatocyte)がみられる。 |
| 6 | Howell-Jolly小体がみられる。 |
| 7 | Pappenheimer小体がみられる。 |
【ねらいと解説】
末梢血の赤血球形態を提示しました。
赤血球形態の表現や判定の基準については、日本臨床検査技師会・血液形態検査標準化ワーキンググループによる勧告法(1996)をもとに日本検査血液学会標準化委員会・血液形態標準化小員会(2001)が作業を進めています。その詳細は日本検査血液学会のHP(http://www.jslh.com/)に画像を貼付して紹介していますので閲覧下さい。
赤血球形態の評価として、赤血球形態の名称は従来から新しい名称で表現するようにされています。すなわち、標的赤血球 target cellはcodocyteといった具合ですが、これは覚えるしかありません。次に判定基準については比率を提示していますが、特に形態異常として臨床的に重要性が高いものとして、奇形赤血球 poikilocyteを重視しています。それには、球状赤血球 spherocyte、破砕赤血球 schizocyte、涙滴赤血球 dacryocyteが含まれます。
今回は、正常型と大きさの異常、形状の異常を提示しました。
A.は大小不同性のなか、正常よりも大きい赤血球 macrocyteです。大きくなった赤血球は時々卵円形を示し、これらをmacroovalocyteとよび、通常MCV、MCHが増加するようです。
B.は正常型(筆者の血液です)。
C.は破砕赤血球 schizocyteとハウエル・ジョリー小体 Howell-Jolly(H-J) bodyがみられます。破砕赤血球は最小血管障害性溶血性貧血の診断に有効で、Hb血症、Hb尿、血小板、FDP検査を早急に進め原因を追究することになりますので見落とさないことが重要です。H-J小体は、赤芽球の分裂途上で核の破片が生じその一部が赤血球にのっかったものとされますが、摘脾や赤芽球の核分裂異常(巨赤芽球性貧血、MDS)の際にみられるようです。
【解答】
A: 2, 3
B: 1
C: 4, 6
【正解率】
A: 45%
B: 45%
C: 82%
形態マガジンTOPへ戻る
「症例12 解答と解説 」 を見る→